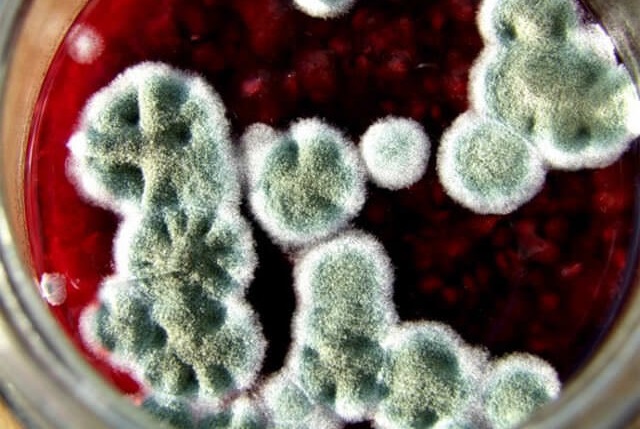
Чтобы закрутки в банках не плесневели: очень простой, но эффективный трюк Черновик

Лимоны — один из самых «ходовых» продуктов в практически любом доме — многие делают очищающий напиток каждое утро с лимонным соком, добавляют лимон в блюда и выпечку, напитки и средства по уходу за собой. Но в отличие от лимонного сока и мякоти, кожуру мы чаще всего выкидываем, не задумываясь над тем, насколько она полезна и насколько широко её применение. Ниже я представляю вашему вниманию несколько советов на тему «как использовать кожуру лимона» в хозяйстве, на кухне и для поддержания красоты и здоровья. Надеюсь, что-то из собранного мной материала вам пригодится.
Как использовать лимонную цедру: кулинария
Наверное, это — самый распространённый вариант использования лимонной цедры. И не удивительно, ведь именно в ней сконцентрированы витамины и минералы и клетчатка (кальций, калий, Витамин С).
- Лимонная цедра
Лимонная цедра улучшит вкус как десертов, так и мясных и овощных блюд. Лучше всего свежую и тщательно вымытую кожуру лимона натереть на тёрке и заморозить небольшими порциями для дальнейшего использования.
- Пряная соль

Очень интересный рецепт — пряная соль с лимоном и смесью перцев. Для приготовления нам потребуется: треть стакана смеси перцев сушёной (продаётся в любом магазине), цедра 4 лимонов и стакан соли. Натираем цедру как можно мельче. Смешиваем с перцем и оставляем до высыхания и измельчаем в блендере. Затем смешиваем пряности с солью (желательно морской) и пересыпаем в герметично закрывающуюся баночку. Можно добавлять в любые блюда.
- Цукаты из лимона



- Отделите кожуру от белой мякоти и нарежьте тоненькими полосками. Затем поместите в кастрюльку, залейте водой и поставьте на огонь. Довести до кипения и оставить на 30 секунд.Затем с огня снять, слить воду и отбросить корки на салфетку для просушки. Повторите ту же процедуру ещё раз.

- Кипячение помогает избавиться от горчинки, которая содержится в кожуре лимона, а также от пестицидов. После того, как вы закончили с кипячением, наливаем в кастрюльку 4 стакана воды, всыпаем туда 3 стакана сахара, нагреваем до растворения последнего.

- После этого добавьте в сироп корки и доведите до кипения.
Далее убавляем огонь на минимум и варим кожурки час-полтора ( в зависимости от размеров и толщины полосок лимонной кожуры), помешивая каждые 15 минут. Дошедшая до готовности кожура лимона становится полупрозрачной. Не дошедшая до готовности кожура, как правило, немного горчит.
Вынимаем кожурки из сиропа и подсушиваем. Сироп сливаем в банку — его можно использовать для создания напитков и коктейлей.
Липкие кожурки обваливаем в сахаре и оставляем на противне, застеленном пергаментной бумагой до полного высыхания.




Очень вкусно сочетание карамелизированной лимонной кожуры с растопленным белым шоколадом.


Как использовать лимонную цедру:
- Лимонный сахар
Сахар со свежим и приятным ароматом лимона — что может быть лучше? Для того, чтобы приготовить такой сахар, нам понадобится: пластиковый пакет с застёжкой, 2-3 стакана сахара и свежая цедра нескольких лимонов.
Хочу отметить, что чем больше цедры, тем насыщеннее у сахара будет лимонный вкус и аромат. Как приготовить лимонный сахар: пересыпать сахар-песок в пакет с застёжкой и туда же отправить свежую цедру, хорошенько перемешайте и оставьте на несколько часов в открытом пакете, чтобы сахар немного посох (пары часов будет достаточно). Далее закрываем пакет, встряхиваем сахар как следует и отправляем на хранение в сухое тёмное место.
Вместо лимонной цедры можно использовать цедру любых других цитрусовых.
- Оливковое масло, настоянное на лимонной цедре
Оливковое масло, настоянное на лимонной цедре, делается очень просто: насыпаем в стеклянную тару свежайшую лимонную цедру, заливаем маслом и оставляем на две недели в тёмном месте. Крышкой лучше не закрывать. Время от времени взбалтываем цедру. Далее процеживаем масло, предварительно помяв цедру в бутылке с маслом черенком деревянной ложки (чтобы вышли все эфирные масла). Процеженное лимонно-оливковое масло храним в стеклянной бутылке с закрытой крышкой.
- Лимонная настойка
Приятная на вкус лимонная настойка — ещё один отличный вариант использования лимонной цедры. Как приготовить: на 250 мл водки берём свежайшую цедру 6 лимонов, смешиваем эти ингредиенты в стеклянной бутылке, плотно закрываем и оставляем настаиваться 4-6 недель в зависимости от того, какой насыщенности нам нужен цитрусовый вкус.
- Лимонная цедра в кубиках льда
Прекрасным дополнением к напиткам и коктейлям, особенно летним, будет несколько кубиков льда, в которые мы добавим мелкую цедру лимона. Также можно нарезать кожуру лимона тонкими полосками и заморозить их для того, чтобы добавлять в коктейли даже без льда.
- Масло с цедрой и пряными травами
-
Сушёную или свежую зелень и мелко натёртую цедру лимона смешайте со сливочным маслом (при помощи блендера или просто мелко порубить ножом).
-
Выложить массу с одного края листа пергаментной бумаги и скатать его в рулет, хорошенько утрамбовывая масло. Затем поместите рулет в бумаге в холодильник на несколько часов и пряное масло с лимонной цедрой готово к использованию.
- Лимонный сахар, которому не страшна влажность
Если добавить цедру лимона в контейнер с коричневым сахаром, то он никогда не спрессуется, всегда будет мягким и рассыпчатым.
Как использовать лимонную цедру: чистота в доме
- Цитрусовый уксус — совершенно натуральное, универсальное и эффективное чистящее средство
Лимонный уксус отлично справляется с любого вида пятнами и загрязнениями, он эффективно расщепляет жир и дезинфицирует. Для того, чтобы сделать лимонный уксус в домашних условиях, нам потребуется обычный столовый уксус (90%), цедра нескольких лимонов, стеклянная тара с крышкой и 2 недели времени. В тару насыпаем цедру, наливаем уксус, встряхиваем и даём настояться 2 недели, не забывая встряхивать время от времени. Далее полученную жидкость можно процедить и разбавить водой в пропорции 50 на 50. Хотя, последний шаг можно опустить, если вы собираетесь чистить лимонным уксусом особо загрязнённые поверхности или дизинфицировать сантехнику.
11. Устранение неприятных запахов в холодильнике
Для того, чтобы избавиться от неприятных запахов в холодильнике, регулярно кладите на полки свежие корки лимона, они впитают все неприятные запахи, оставив взамен свежесть и лёгкий цитрусовый аромат.
12. Устранение неприятного запаха мусорного контейнера
Как и в случае с холодильником, корки лимона впитывают неприятные запахи, пропитавшие мусорный контейнер, оставляя свежий цитрусовый аромат.
13. Корки лимона можно также использовать вместо губки при удалении известкового налёта и прочих загрязнений с металлических и керамических поверхностей.
14. При помощи корки лимона можно эффективно очистить тёрку даже от застарелой грязи. Стоит только протереть на неё кожуру лимона, оставить для воздействия на несколько минут и смыть водой.
Как использовать лимонную цедру: красота и здоровье
15. Если смешать мелко натёртую лимонную цедру с коричневым сахаром и добавить в смесь немного оливкового масла, то у вас получится отличный увлажняющий скраб, который поможет вам эффективно ухаживать за кожей лица и тела.
16. Для того, чтобы отбелить пожелтевшие ноги, потрите их свежей кожурой лимона — и результат вас очень порадует.
17. С помощью лимонной кожуры также можно осветлить возрастные пятна и веснушки — следует только регулярно протирать свежей коркой проблемные места. Кстати, такая процедура позволяет придать коже лица ровный, красивый тон.
18. Сухую кожу на локтях можно смягчить при помощи лимонной корки — для этого стоит немного помять корку в руке и потереть ею проблемное место.
19. Лимонную цедру можно добавлять в смесь для бомбочек для ванны, душа или сантехники — все варианты изготовления таких полезных косметических средств можно найти здесь.
20. Также лимонную цедру можно использовать при изготовлении домашнего мыла.